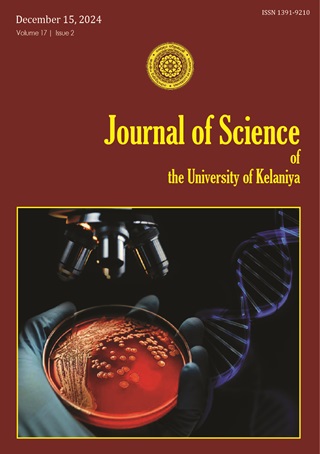
2024 | Volume 17 | ISSUE II

About the Journal
Journal of Science of the University of Kelaniya (JOSUK) is a peer-reviewed, open-access journal published by the Faculty of Science of the University of Kelaniya. This Journal publishes two issues per year in May and December.
The journal has a wider coverage of subject areas of all aspects of science. The journal accepts original research work as research articles and short communications.
The Journal of Science of the University of Kelaniya is indexed in Sri Lanka Journals Online (SLJOL) and Google Scholar.
The journal has a wider coverage of subject areas of all aspects of science. The journal accepts original research work as research articles and short communications.
The Journal of Science of the University of Kelaniya is indexed in Sri Lanka Journals Online (SLJOL) and Google Scholar.
Copyright and license :
Creative commons attribution![]()

Quick Links
Latest Publication
Department of Zoology and Environmental Management
Faculty of Science
University of Kelaniya
Kelaniya GQ11600,
Sri Lanka
Email: eic_jsuk@kln.ac.lk
Teliphone: (+94) 112 914479